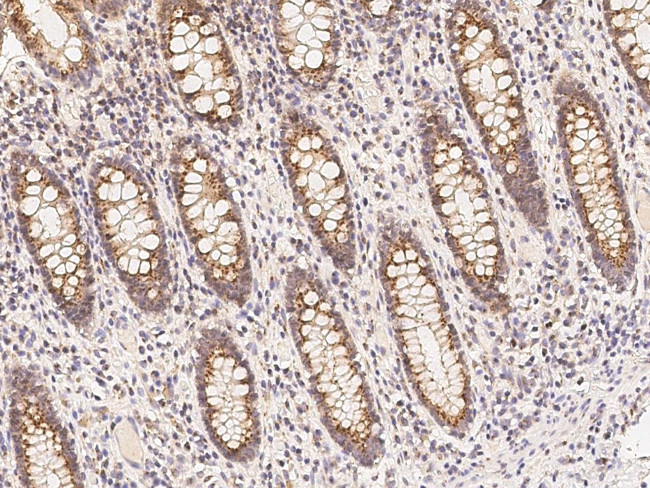
Claudin 3 Antibody in Immunohistochemistry (Paraffin) (IHC (P))

Search
Invitrogen
Claudin 3 Polyclonal Antibody
{{$productOrderCtrl.translations['antibody.pdp.commerceCard.promotion.promotions']}}
{{$productOrderCtrl.translations['antibody.pdp.commerceCard.promotion.viewpromo']}}
{{$productOrderCtrl.translations['antibody.pdp.commerceCard.promotion.promocode']}}: {{promo.promoCode}} {{promo.promoTitle}} {{promo.promoDescription}}. {{$productOrderCtrl.translations['antibody.pdp.commerceCard.promotion.learnmore']}}


Please note: We are reviewing Western blot images included in the antibody testing data in our catalog, including those provided by third parties. Unless expressly labeled or annotated as “raw-unedited”, Western blot images included in the antibody testing data in our catalog may have been edited, optimized or otherwise adjusted for presentation.
产品信息
PA5-80480
种属反应
宿主/亚型
分类
类型
抗原
偶联物
形式
浓度
规格
纯化类型
保存液
内含物
保存条件
运输条件
RRID
产品详细信息
This product is preservative free. It is recommended to add sodium azide to avoid contamination (final concentration 0.05%-0.1%).
This antibody has specificity for Human Claudin 3.
靶标信息
Claudin 1-8 proteins are a family of transmembrane proteins associated with tight junctions. Tight junctions are specialized regions of cell to cell contact; made up of network of strands to act as a molecular gasket for preventing the leakage of ions, water etc. between cells. They are abundant in luminal epithelial sheets where they maintain epithelial cell polarity. Different tissues exhibit different Claudin composition. Differential expression of this gene has been observed in different types of malignancies, including breast cancer, ovarian cancer, hepatocellular carcinomas, urinary tumors, prostate cancer, lung cancer, head and neck cancers, thyroid carcinomas, etc. Alternatively spliced transcript variants encoding different isoforms have been found.
仅用于科研。不用于诊断过程。未经明确授权不得转售。
篇参考文献 (0)
生物信息学
蛋白别名: Claudin-3; Clostridium perfringens enterotoxin receptor 2; CPE-R 2; hRVP1; Rat ventral prostate.1 protein homolog
基因别名: C7orf1; CLDN3; CPETR2
Entrez Gene ID: (Human) 1365